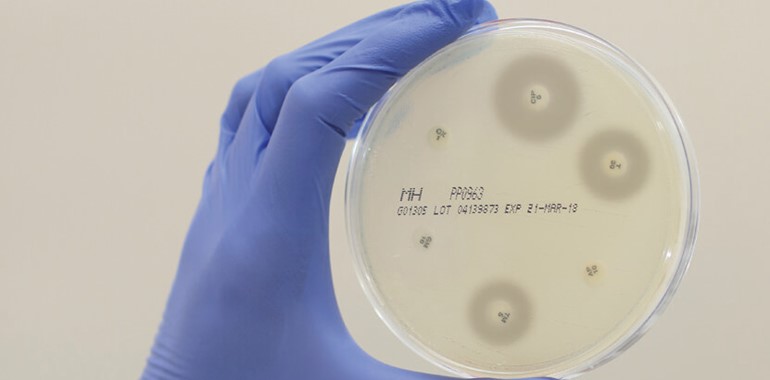

MASTDISCS® - Quality and Experience
Mast Group Ltd. has been manufacturing AST discs for over 60 years, with a history of experience, quality and innovation, the expansion of the portfolio has resulted in the most comprehensive range available world-wide.
Disc diffusion is still the most popular method for determining bacterial antibiotic susceptibility in the treatment of infectious disease, as highlighted by EUCAST and CLSI. Accordingly, in a recently published paper by EUCAST, Mast Group Ltd.’s discs were found to ‘demonstrate excellent and consistent quality in both the 2014 and 2017 studies.
MASTDISCS® AST recorded results 100% within the ranges set out by EUCAST and reproducibility continues to be of a high standard for all QC combinations (Ahman et al., 2018).
As described by Humphries et al., antimicrobial discs are among the first AST devices available to clinical laboratories when new antimicrobials are approved. The use of disc diffusion for new antimicrobials allows laboratories to assess and customise antimicrobials tested depending on local resistance distributions, and to support antibiotic stewardship. In contrast automated systems are generally available with pre-defined panels. In the current climate where there is a shortage of antibiotics, antibiotic discs are the ideal solution to integrate new agents into routine disc testing protocols.
For more information about the full range of MASTDISCS® please contact us using the button at the bottom of this page.
Ahman, J., Matuscheck, E., Kahlmeter, G. (2018) The quality of antimicrobial disks from nine manufacturers -EUCAST evaluations in 2014 and 2017. Clinical Microbiology and Infection (25), 346-352
Humphries, R.M. et al (2018) The continued value of disk diffusion for assessing antimicrobial susceptibility in clinical laboratories: report from the Clinical and Laboratory Standards Institute Methods Development and Standardization Working Group. J. Clin. Microbiol. doi:10.1128/JCM.00437-18
